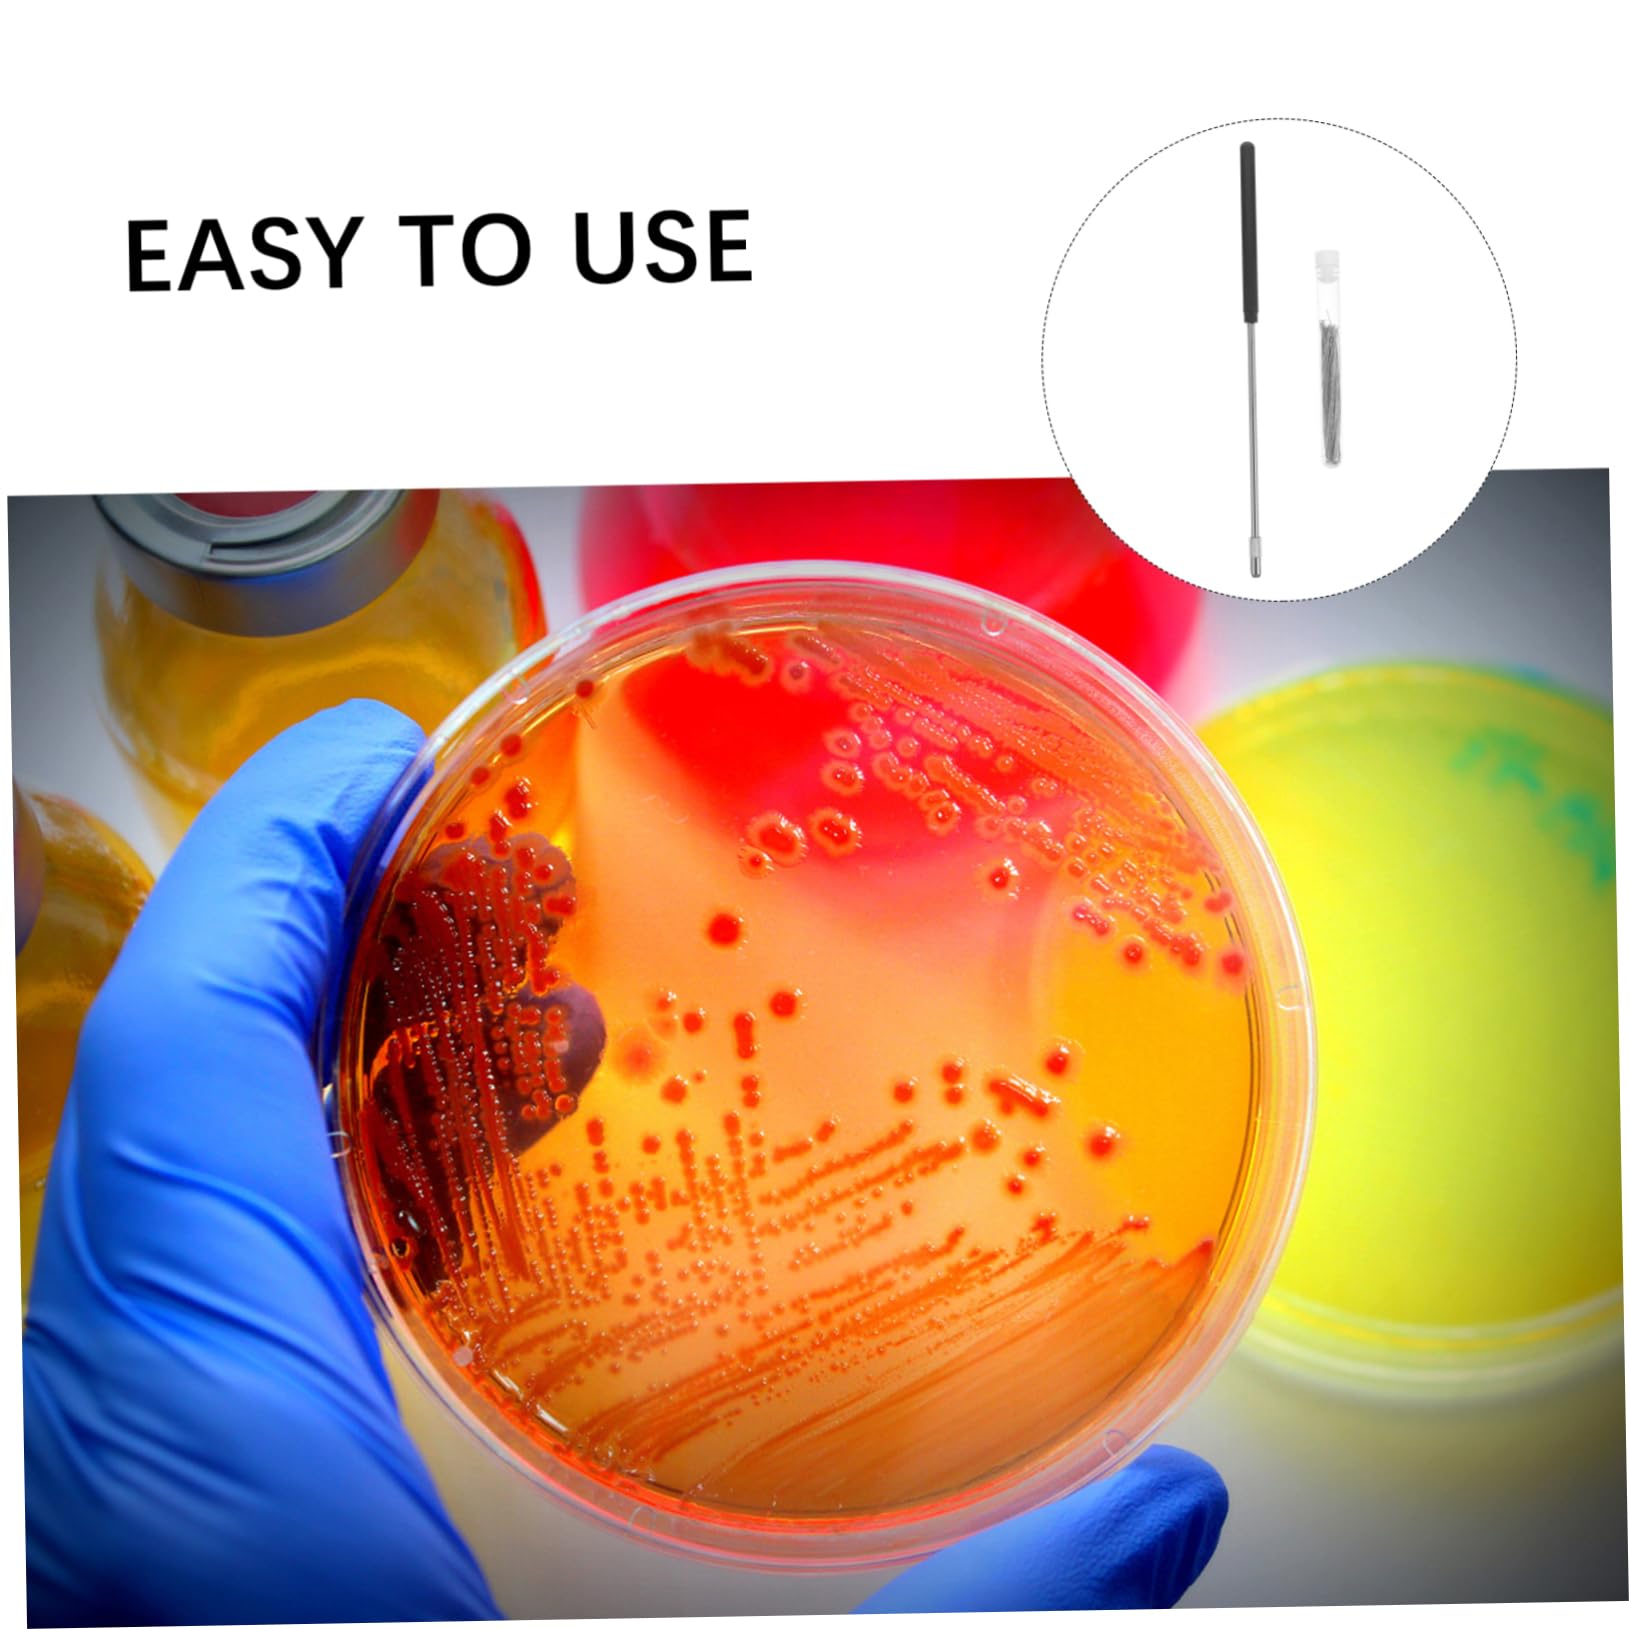

Welcome to PausenColor
Where Creativity Meets Vibrant Innovation
Since 2008, PausenColor has been revolutionizing the world of color with our premium paint collections, cutting-edge digital color matching technology, and expert consultation services. We've helped over 50,000 customers transform their spaces with colors that inspire, energize, and create lasting impressions.
Featured Collections
Discover our most popular color collections, each carefully curated by our team of color experts and tested in real-world environments to ensure stunning, long-lasting results.

Premium Paint Collection
Professional-grade paints with unmatched vibrancy and durability. Our signature collection features 150+ colors with advanced stain resistance and 15-year fade protection.

Digital Color Tools
Revolutionary AI-powered color matching and visualization software. Upload photos, scan colors, and see realistic previews before you paint with 99.8% accuracy.

Expert Consultation
Personalized color consultation with certified color specialists. Get professional advice, mood boards, and complete color schemes tailored to your space and lifestyle.
Why Choose PausenColor?
We're not just another paint company. We're color innovators, sustainability champions, and your partners in creating spaces that truly reflect who you are.

Eco-Friendly Innovation
Our zero-VOC formulations are safe for your family and the environment. Made with renewable materials and recyclable packaging, we're committed to a sustainable future without compromising on quality or performance.

Advanced Color Science
Our in-house color laboratory uses spectrophotometry and AI algorithms to create colors that maintain their vibrancy for decades. Every shade is tested under multiple lighting conditions to ensure consistent beauty.

Lifetime Support
From initial consultation to touch-up advice years later, our certified color experts are here to help. Get personalized recommendations, application tips, and ongoing support for all your color projects.

Trusted by Thousands
Our commitment to quality and innovation has made us the preferred choice for homeowners, designers, and architects worldwide.
What Our Customers Say
Real stories from real customers who have transformed their spaces with PausenColor.

Sarah Johnson
Interior Designer
"PausenColor's digital color matching tool saved me countless hours on my latest project. The accuracy is incredible, and my clients were amazed by how perfectly the colors matched their vision."

Michael Chen
Homeowner
"We painted our entire house with PausenColor's eco-friendly line. Three years later, the colors still look as vibrant as day one. Plus, knowing it's safe for our kids gives us peace of mind."

Emma Rodriguez
Architect
"The consultation service exceeded my expectations. Their color expert helped us create a cohesive palette that perfectly captures our brand identity across all our office spaces."


:max_bytes(150000):strip_icc()/professional-color-analyst-experience-GettyImages-1188217403-9ae6f0ff5ae34853a55a7372232448ff.jpg)